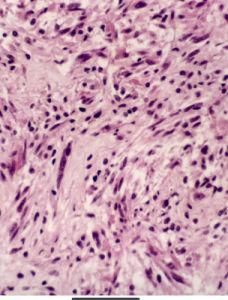
膠質母細胞瘤

病因
膠質母細胞瘤發病機制
腫瘤好發於大腦半球白質內,浸潤性生長,外觀呈半球形分葉狀,大多數腫瘤境界不清,少數腫瘤因生長迅速而使周圍組織受壓出現軟化和水腫 表現“假包膜”現象,可被誤以為境界清楚,其實腫瘤已超出邊界浸潤生長。腫瘤可侵犯皮質並可與硬膜粘連,或可突入腦室及深部結構。由於腫瘤浸潤性擴張,膠質母細胞瘤常表現為多中心生長。但研究表明,真正多中心生長的膠質母細胞瘤只占2%~5% 腫瘤多沿神經纖維傳導束生長,可沿胼胝體侵犯對側腦組織,形成蝶形生長, 同樣通過沿丘腦間黏合生長 可出現雙側丘腦膠質母細胞瘤。
腫瘤的硬度因腫瘤有無繼發性改變而異,一般軟硬相間,質地不均。腫瘤可呈多種顏色,瘤內常有囊變 壞死及出血,鈣化少見。典型腫瘤切面可見灰色的瘤體、紅色的新鮮出血、紫色的出血塊、黃色的陳舊出血和白色的間質增生,腫瘤亦可有大小不一的壞死灶和囊性變,囊內液體可呈血性 棕色、或黃色,也可為散在於腫瘤實質區內的多個小囊, 腫瘤血運豐富,周圍腦水腫明顯。突出到腦表面和腦室者, 腫瘤細胞可隨腦脊液播散,個別的可向腦外轉移至肺、肝、骨或淋巴結。
圖1 膠質母細胞瘤膠質母細胞瘤組織表現複雜,形態不一,同一腫瘤的不同部位亦不一致。根據WH0(1990)提出的分類標準,膠質母細胞瘤分為以下兩個組織學亞型:①巨細胞型膠質母細胞瘤。②膠質肉瘤。這些亞型的提出,主要是根據腫瘤的某些比較突出的形態特徵而定,與患者的預後無肯定的相應關係。
腫瘤細胞有多種組織學形態。增殖的腫瘤細胞常以小而深染的圓細胞為主,伴以間變的未分化的纖維性, 原漿性與肥胖性星形細胞,另有大而怪異的來源不明的瘤細胞。腫瘤細胞直徑相差懸殊, 大者可達30μm以上, 小者可能不足10μm。部分腫瘤胞質十分豐富,亦有胞質完全缺如而呈裸核者,核多形性並有較多分裂象。腫瘤壞死區被成堆狹長的腫瘤細胞層層環繞。腫瘤細胞核分裂象相當多見,並可見到單核或多核瘤巨細胞。供血的血管豐富,在腫瘤細胞增殖旺盛的區域內, 可出現血管內皮細胞的異常增殖,形成圍繞的血管球,與腎小球相似,構成膠質母細胞瘤鏡下的另一個特徵。來源於血管外膜細胞的間質纖維增生,嚴重者可成為腫瘤成分。
少數腫瘤可有蛛網膜下腔播散,10%~20%膠質母細胞瘤患者腦脊液中可發現腫瘤細胞。有軟腦膜種植者約10%,屍檢中達30%。開顱行腫瘤切除術後的患者極少數可發生腫瘤顱外轉移。
電鏡下腫瘤細胞大小形狀不一,形態呈原始低分化,核大而周質少, 細胞器稀少但多聚核糖體豐富, 核不規則 核仁突出,常見核分裂象 巨細胞的細胞膜常有摺疊,有時可見大量微絨毛,細胞器多少不固定, 核畸形、 多形、或分葉,高度不規則。巨細胞型膠質母細胞瘤的胞質極為寬闊,充滿大量膠質絲 方向不定,成熟程度不一,線粒體散在其中 糖原豐富,核染色質與核仁突出,毛細血管和小血管內皮增生呈球狀,使血管腔閉鎖 大血管內皮都有增生,多層基膜包繞,大量膠質纖維產生。常見腫瘤細胞有不同程度的壞死,壞死灶中和血管周圍常見巨噬細胞、成纖維細胞和其他炎性細胞。
流行病學
膠質母細胞瘤占神經上皮性腫瘤的50%~55%,占成人顱內腫瘤的25%。本病主要發生於成人, 成人中以45~65歲最為多發,30歲以下年輕患者少見。男性明顯多於女性,男女發病比例為3∶2,在老年患者中男性患者多見。膠質母細胞瘤可發生於中樞神經系統任何部位,但以額顳部多見,這可能與額顳葉間有大量神經纖維聯繫有關。後顱窩膠質母細胞瘤少見,位於小腦者僅占膠質母細胞瘤的0.24%。
臨床表現
圖2 膠質母細胞瘤併發症
如進行手術治療, 可能發生以下併發症:
1.顱內出血或血腫 與術中止血不仔細有關,隨著手術技巧的提高,此併發症已較少發生。創面仔細止血, 關顱前反覆沖洗, 即可減少或避免術後顱內出血。
2.腦水腫及術後高顱壓 可用脫水藥物降低顱內壓,糖皮質激素減輕腦水腫。對於病變範圍廣泛或惡性程度高的腫瘤可儘可能多切除腫瘤及非功能區腦組織行內減壓,同時去骨瓣外減壓。
3.神經功能缺失 與術中損傷重要功能區及重要結構有關,術中儘可能避免損傷,出現後對症處理。
診斷
膠質母細胞瘤切片示意圖鑑別診斷:無特殊。
實驗室檢查
腰穿多提示壓力增高,腦脊液蛋白含量增高及白細胞增多,少數病例特殊染色有時可發現脫落的腫瘤細胞。腰穿時病人顱內壓較高應注意防止腦疝的形成。
其它輔助檢查
1.放射性核素檢查 診斷陽性率較星形細胞瘤為高,病變局部顯示放射性濃區。頭顱 X 線平片僅顯示顱內壓增高 偶見松果體鈣化後的移位, 腦血管造影見血管受壓移位,約半數顯示病理血管,病變處血管多粗細不均、扭曲不整,有的呈細小點狀或絲狀。
2.CT掃描 腫瘤呈邊界不清的混合密度病灶,其中多有瘤內出血所致高密度表現但鈣化者較少 瘤內壞死及囊性變呈低密度影,而使其形態呈多形性,病灶周圍多數腦水腫較重, 腫瘤與腦組織無明顯邊界。腦室常被壓迫變小,變形或封閉,中線結構常向對側移位。增強後95%的腫瘤呈不均勻強化 常表現為中央低密度的壞死或囊變區 周邊增生血管區不規則的環形、島形或螺鏇形強化影(圖1)。壞死區常位於腫瘤實質內,呈邊界不整齊的低密度區。
3.MRI檢查 腫瘤在T1加權圖像上呈低信號,T2W像為高信號的邊界不清的腫瘤影(圖2),與鄰近腦組織不容易區分,占位效應十分明顯。腫瘤內若有較大的壞死區則呈更低信號,若有出血呈高信號。胼胝體常受累 中線結構如縱裂池可變形、變窄或移位。腫瘤在T2加權像呈混雜信號,以高信號為主,散在性分布低與等信號。注射 Gd-DTPA 後腫瘤十分顯著的對比增強使得腫瘤與鄰近結構有明確的分界,且好發在腦深部,是較為特徵性的表現。
治療及預後
膠質母細胞瘤每個患者均應行術後常規放療,也可合併套用化療或免疫治療 近來有文獻報導手術後即進行放療, 在放療後每隔2個月化療1次,同時予以免疫治療,可使部分病人獲得較長時間的緩解期。
膠質母細胞瘤表現一定的放療耐受性,對於殘餘的腫瘤多採用高劑量分割照射、腫瘤間質內放療和立體定向放射外科來實現, HFRT能將傳統外放射劑量提高到70.2~72Gy,而不產生放射性壞死,增強了抑制腫瘤復發的能力 125I質粒的立體定向植入(間質內放療)配合HFRT能夠顯著提高治療效果,優於傳統外放療和化療的組合。膠質母細胞瘤對不同的化療敏感率是40%~80%,利用大劑量多種化療藥聯合衝擊治療後輔助以自體骨髓移植來減少化療副反應也證明是可行的。小兒膠質母細胞瘤術後3年內腦脊液播散率為(26±7)%,局部復發率為69%,二者同時發生也常見, 對手術後輔以腦脊髓照射和局部追加照射也是可行的。近來,對膠質母細胞瘤的免疫治療、基因治療的報告也有許多, 但因治療方法和效果評價標準的不統一, 效果均不十分肯定,只能作為綜合治療手段的一部分,無法代替放化療。
預後
因腫瘤惡性程度高,術後易復發 膠質母細胞瘤患者預後差 95%未經治療的患者生存期不超過3個月, 患者的預後與多因素有關。患者年齡在45歲以下,術前症狀超過6個月,症狀以癲癇為主而非精神障礙, 腫瘤位於額葉及術前狀況較好者生存期稍長。腫瘤切除程度影響患者生存期, 部分切除或行腫瘤活檢者術後6個月及2年的生存率為肉眼腫瘤全切的患者的一半, 肉眼腫瘤全切除對改善患者神經系統症狀有幫助, 放療可延長患者的生存期4~9個月,術後放療可使部分患者生存期達18個月。然而,雖然對膠質母細胞瘤的綜合治療可暫時緩解病情進展,但不能治癒腫瘤,膠質母細胞瘤患者經腫瘤肉眼全切, 放療、化療等綜合治療後,2年生存率為10%,僅有不到5%的病人可長期生存。